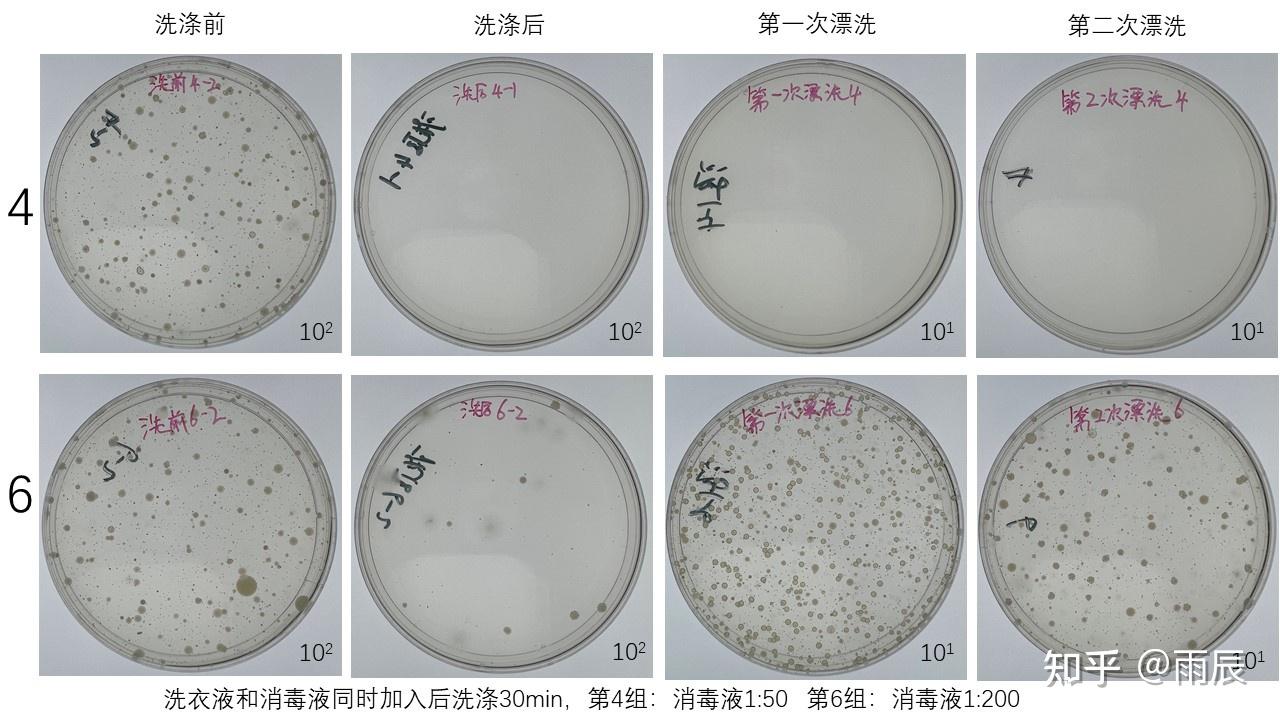

簡述滅菌效果檢測的內容 ?實驗室實測告訴你,消毒液和洗衣液能不能同時使用 健明迪檢測
簡述滅菌效果檢測的內容??實驗室實測通知你,消毒液和洗衣液能不能同時運用? 健明迪檢測
南京西格瑪醫學:家用IVD的設計應著眼于器械功用不會遭到用戶技術或檢測環境預期變化的清楚影響。例如:合理預見用戶停止測試操作方式的變化;合...實驗室實測通知你,消毒液和洗衣液能不能同時運用?
我們日常用于衣物消毒的消毒成分主要有兩類,一類是運用*普遍的對氯間二甲苯酚(PCMX)類消毒液,另一類是*近幾年盛行的季銨鹽類消毒液。其中季銨鹽類成分屬于陽離子,而市面上的絕大局部洗衣液都含有陰離子成分,陰離子的洗衣液和陽離子的消毒液混合在一同運用會發生沉淀而失活,所以這類消毒液是不能和消毒液混用的。對氯間二甲苯酚(PCMX)類消毒液和洗衣液混合不會出現沉淀的效果,混合運用消毒效果會有區別嗎?
籌劃了良久的實驗室模擬洗濯的初步實驗終于做完了,實驗只能是盡量模擬洗衣機洗的的進程,總共做了8組實驗,模擬了在洗衣機中同時參與洗衣液和消毒液混合洗濯消毒,以及先加洗衣液洗濯在第二次漂洗的時分參與消毒液消毒(在洗衣機柔順劑槽中參與消毒劑),消毒液的稀釋比例區分按運用說明引薦的1:50倍稀釋和1:200倍稀釋(很多人習氣的加1~2瓶蓋大約是在這個量)。
復雜引見一下實驗進程
1.純棉白布用純真水洗濯潔凈后晾干,剪成5cm*10cm大小,對折后平均滴加上從空氣中搜集培育后的菌液,再晾干。
2.250ml三角瓶中裝入50ml無菌水和5顆鋼珠,8組染菌后的布樣放入三角瓶中后,搖床中200rpm振蕩10min后,洗去1ml至裝有9ml無菌PBS試管中,10倍稀釋2次后取1ml稀釋液至培育皿中倒入NA培育基培育,此為洗濯前培育。
3.再在8組三角瓶中按下表中洗衣液/消毒液的添加量添加相應的添加物后,200rpm搖床中振蕩按表中的要求模擬洗濯/漂洗,在洗濯30min后、*次漂洗、第二次漂洗后,從三角瓶在區分取1ml液體,做細菌培育。
4.參與消毒液后洗濯/漂洗的流程完畢后的取樣采用中和劑中和10min后在做細菌培育(中和劑為含組氨酸0.5%、Tween-80 2%、卵磷脂0.2%的PBS溶液)。
結果
之前在其他的效果下有詳細引見過洗衣時消毒液運用的幾種方式
第1組是用清水洗漂,第2組正常加洗衣液洗漂,兩組在洗濯流程完畢后的漂洗水中依然有少量活菌,第2組和第1組結果簡直沒有差異,實際下去說靠機械力洗衣液里表活的包裹和三次水的沖刷,整個洗濯進程確實是能去除掉衣服上的大局部細菌,出現這種結果能夠是由于這種振蕩與洗衣機的攪拌的機械力發生的作用相差很大,還無機洗衣服時衣服之間有相互摩擦,而模擬實驗布片缺少摩擦,所以清水和洗衣液對自然菌的洗除效果比擬差。
這兩組模擬的是消毒液放入柔順劑槽中,先加洗衣液正常洗濯后,在第二次漂洗的時分柔順劑槽中的消毒液會進入洗衣機中,第二次漂洗從進水到排水的時間在5分鐘左右,所以這種方式消毒的作用時間在5min左右。第3組洗濯和*次漂洗后的結果與第1組第2組差不多,第二次漂洗時按1:50稀釋參與消毒液后,培育結果未見細菌生長,說明消毒液起到了很好的消毒效果。第5組是按1:200稀釋參與消毒液,從培育結果可以看出較低濃度的消毒液和較短的消毒時間消毒液簡直起不到消毒作用。
這兩組模擬的是洗衣液和消毒液一同放入洗衣機,洗濯和消毒同時停止,第4組按1:50稀釋參與消毒液,30min的洗濯完畢后,培育未見細菌生長說明消毒有起到了很好的消毒效果。而第6組是按1:200稀釋參與消毒液,洗后依然有少量細菌及霉菌生長,沒有依照運用說明引薦的運用量,消毒液未能到達消毒效果,但是和第5組比,30min作用時間要比5min作用時間的殺菌效果好。
這兩組只用消毒液消毒。第7組按1:50稀釋參與消毒液,作用30min后,培育未見細菌生長,說明消毒有起到了很好的消毒效果。第8組是按1:200稀釋參與消毒液,殺菌效果要比第7組差很多,低濃度消毒劑延伸消毒時間能提高殺菌效果。此外,第8組培育基上生長的主要是霉菌,說明此消毒液對真菌的殺滅效果較差。第6組結果和第8組結果相比,這兩組的都達不到消毒的效果,但是第8組的效果要優于第6組,說明洗衣液和消毒液混用確實會降低消毒液的殺菌效果。
結論
1.假設是依照說用說明引薦的稀釋比例運用對氯間二甲苯酚(PCMX)消毒液,洗衣液和消毒液同時運用或許是先洗濯后消毒或獨自消毒液浸泡這幾種方式都能到達十分好的消毒效果,有沒有分開運用差異不大。
2.依照很多人慣例的運用消毒液的劑量,洗衣液和消毒液同時運用或許是先洗濯后消毒或獨自消毒液浸泡都不能到達消毒效果。
3.低濃度消毒液的條件下證明,洗衣液和消毒液混用會降低消毒液的殺菌效果。
*后附上測試所用消毒液的運用說明:
簡述滅菌效果檢測的內容??實驗室實測通知你,消毒液和洗衣液能不能同時運用? 健明迪檢測
消毒劑需求做什么檢測?檢測規范是什么?
隨著新冠病毒的迸發,人們也末尾注重周圍生活環境的衛生,進出公共場所都是需求停止消毒液清潔,眾所周知,隨著中國不時地開展,如今的市場把控也十分嚴厲,任何產品出售都是需求經過國標的嚴厲把控,消毒劑自然也不例外,明天我們經過訊科檢測的化學剖析工程師了解到有關于消毒劑檢測的相關知識。
消毒劑的檢測項目有:
1、理化功用測試(有效成分、動搖性實驗、pH值、重金屬(砷、鉛、汞)、金屬腐蝕性、延續運用動搖性實驗);
2、病毒殺滅實驗(脊髓灰質炎病毒滅活實驗、流感病毒滅活實驗、手足口病毒滅活實驗等)
3、微生物目的(細菌菌落總數、大腸菌群、真菌菌落總數、致病性化膿菌)
4、毒理學平安目的測試(急性經口毒性實驗、急性吸入毒性實驗、屢次完整皮膚撫慰實驗、一次完整皮膚撫慰實驗、一次破損皮膚撫慰實驗、皮膚變態反響實驗、眼撫慰實驗、陰道粘膜撫慰實驗、亞急性毒性實驗)
經過抵消毒劑檢測的了解,我們了解到如今的生活環境是十分平安的,置信隨著水平提高,新冠病毒也會很快地被消滅。